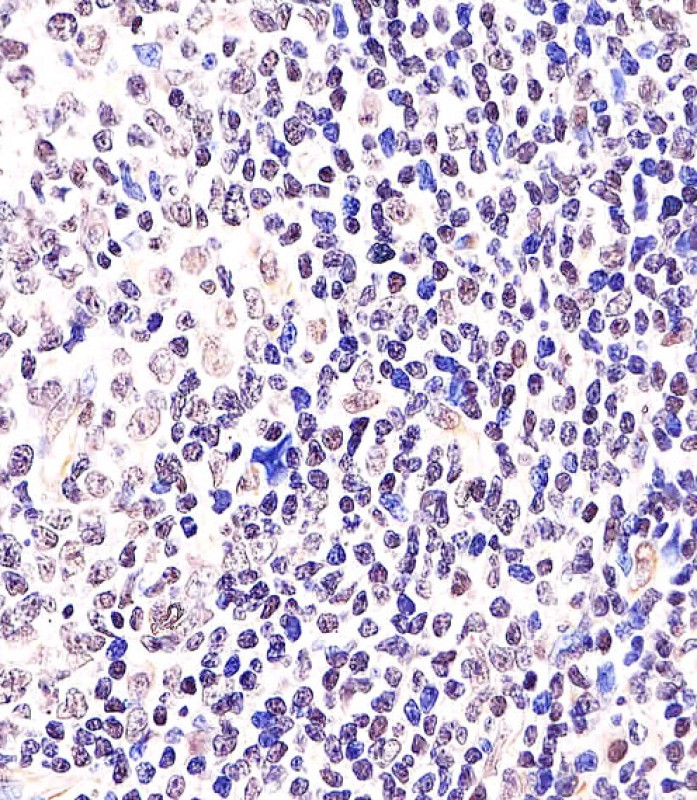

> Antigen, Antibodies, ELISA, Western Blot > Primary Antibody > Polyclonal Antibodies > BCL6 Antibody (Center)Brand |
Leading Biology | Catalog Number |
APR04907G |
Product Type |
Polyclonal Antibodies | Field of Research |
|
Product Overview |
We constantly strive to ensure we provide our customers with the best antibodies. As a result of this work we offer this antibody in purified format.
We are in the process of updating our datasheets. If you have any questions regarding this update, please feel free to contact our technical support team.
This product is a high quality BCL6 Antibody (Center).
|
||
Molecular Weight |
78846 Da
|
||
Cellular Localization |
Antigen Cellular Localization:
Nucleus
|
||
Host |
Rabbit
|
||
Species Reactivity |
Human, Mouse
|
||
Target |
This BCL6 antibody is generated from a rabbit immunized with a KLH conjugated synthetic peptide between 364-395 amino acids from the Central region of human BCL6.
|
||
Isotype |
Rabbit Ig
|
||
Symbol |
BCL5, LAZ3, ZBTB27, ZNF51
|
||
GeneID |
|||
UniProt ID |
|||
Function |
Transcriptional repressor mainly required for germinal center (GC) formation and antibody affinity maturation which has different mechanisms of action specific to the lineage and biological functions. Forms complexes with different corepressors and histone deacetylases to repress the transcriptional expression of different subsets of target genes. Represses its target genes by binding directly to the DNA sequence 5'-TTCCTAGAA-3' (BCL6- binding site) or indirectly by repressing the transcriptional activity of transcription factors. In GC B-cells, represses genes that function in differentiation, inflammation, apoptosis and cell cycle control, also autoregulates its transcriptional expression and up-regulates, indirectly, the expression of some genes important for GC reactions, such as AICDA, through the repression of microRNAs expression, like miR155. An important function is to allow GC B-cells to proliferate very rapidly in response to T-cell dependent antigens and tolerate the physiological DNA breaks required for immunglobulin class switch recombination and somatic hypermutation without inducing a p53/TP53-dependent apoptotic response. In follicular helper CD4(+) T-cells (T(FH) cells), promotes the expression of T(FH)-related genes but inhibits the differentiation of T(H)1, T(H)2 and T(H)17 cells. Also required for the establishment and maintenance of immunological memory for both T- and B-cells. Suppresses macrophage proliferation through competition with STAT5 for STAT-binding motifs binding on certain target genes, such as CCL2 and CCND2. In response to genotoxic stress, controls cell cycle arrest in GC B-cells in both p53/TP53- dependedent and -independent manners. Besides, also controls neurogenesis through the alteration of the composition of NOTCH- dependent transcriptional complexes at selective NOTCH targets, such as HES5, including the recruitment of the deacetylase SIRT1 and resulting in an epigenetic silencing leading to neuronal differentiation.
|
||
Summary |
Transcriptional repressor mainly required for germinal center (GC) formation and antibody affinity maturation which has different mechanisms of action specific to the lineage and biological functions. Forms complexes with different corepressors and histone deacetylases to repress the transcriptional expression of different subsets of target genes. Represses its target genes by binding directly to the DNA sequence 5'-TTCCTAGAA-3' (BCL6- binding site) or indirectly by repressing the transcriptional activity of transcription factors. In GC B-cells, represses genes that function in differentiation, inflammation, apoptosis and cell cycle control, also autoregulates its transcriptional expression and up-regulates, indirectly, the expression of some genes important for GC reactions, such as AICDA, through the repression of microRNAs expression, like miR155. An important function is to allow GC B-cells to proliferate very rapidly in response to T-cell dependent antigens and tolerate the physiological DNA breaks required for immunglobulin class switch recombination and somatic hypermutation without inducing a p53/TP53-dependent apoptotic response. In follicular helper CD4(+) T-cells (T(FH) cells), promotes the expression of T(FH)-related genes but inhibits the differentiation of T(H)1, T(H)2 and T(H)17 cells. Also required for the establishment and maintenance of immunological memory for both T- and B-cells. Suppresses macrophage proliferation through competition with STAT5 for STAT-binding motifs binding on certain target genes, such as CCL2 and CCND2. In response to genotoxic stress, controls cell cycle arrest in GC B-cells in both p53/TP53- dependedent and -independent manners. Besides, also controls neurogenesis through the alteration of the composition of NOTCH- dependent transcriptional complexes at selective NOTCH targets, such as HES5, including the recruitment of the deacetylase SIRT1 and resulting in an epigenetic silencing leading to neuronal differentiation.
|
||
Storage & Stability |
Store at +4°C short term. For long-term storage, aliquot and store at -20°C or below. Stable for 12 months at -20°C. Avoid repeated freeze-thaw cycles.
|
||
Applications |
WB, IHC-P, E
|
||
Dilution |
IHC-P~~1:25
WB~~1:1000
|
||
Images |
APR04907G staining BCL6 in Human tonsil tissue sections by Immunohistochemistry (IHC-P - paraformaldehyde-fixed, paraffin-embedded sections). Tissue was fixed with formaldehyde and blocked with 3% BSA for 0. 5 hour at room temperature; antigen retrieval was by heat mediation with a citrate buffer (pH6). Samples were incubated with primary antibody (1/25) for 1 hours at 37°C. A undiluted biotinylated goat polyvalent antibody was used as the secondary antibody. 
All lanes : Anti-BCL6 Antibody (Center) at 1:1000 dilution Lane 1: mouse spleen lysate Lane 2: Ramos whole cell lysate Lane 3: Raji whole cell lysate Lane 4: Jurkat whole cell lysate Lysates/proteins at 20 μg per lane. Secondary Goat Anti-Rabbit IgG, (H+L), Peroxidase conjugated at 1/10000 dilution. Predicted band size : 79 kDa Blocking/Dilution buffer: 5% NFDM/TBST. |
||
Specification |
|||
Quantity |
|
||
| Select | Brand | Catalog No. | Product Name | Pack Size | Type | Field of Research | Specification | Quantity | Price(USD) | |
| 1 | Leading Biology | APR03440G | ITGA11 Antibody (N-term) | 100 μl | Polyclonal Antibodies |
|
$495.00 | Add Ask | ||
| 2 | Leading Biology | APR04537G | CMIP Antibody (C-term) | 100 μl | Polyclonal Antibodies |
|
$495.00 | Add Ask | ||
| 3 | Leading Biology | APR12422G | Human H4 Histamine Receptor (extracellular) Antibody | 50 μl | Polyclonal Antibodies |
|
$695.00 | Add Ask | ||
| 4 | Leading Biology | APR03844G | UBE2W Antibody (C-term) | 100 μl | Polyclonal Antibodies |
|
$495.00 | Add Ask | ||
| 5 | Leading Biology | APR04349G | HECTD2 Antibody (N-term) | 100 μl | Polyclonal Antibodies |
|
$495.00 | Add Ask | ||
| 6 | Leading Biology | APR03502G | IGHG1 Antibody (Center) | 100 μl | Polyclonal Antibodies |
|
$495.00 | Add Ask |
 Leading Biology Inc.
2600 Hilltop DR, Building G, B Suite C138
Richmond, CA, 94806
Tel: 1-661-524(LBI)-0262
Email: info@leadingbiology.com
Leading Biology Inc.
2600 Hilltop DR, Building G, B Suite C138
Richmond, CA, 94806
Tel: 1-661-524(LBI)-0262
Email: info@leadingbiology.com
Complete this form and click send to ask us a question, request a quote or simply say hello.

You have 0 item in your cart

You have 0 item in your inquiry list
